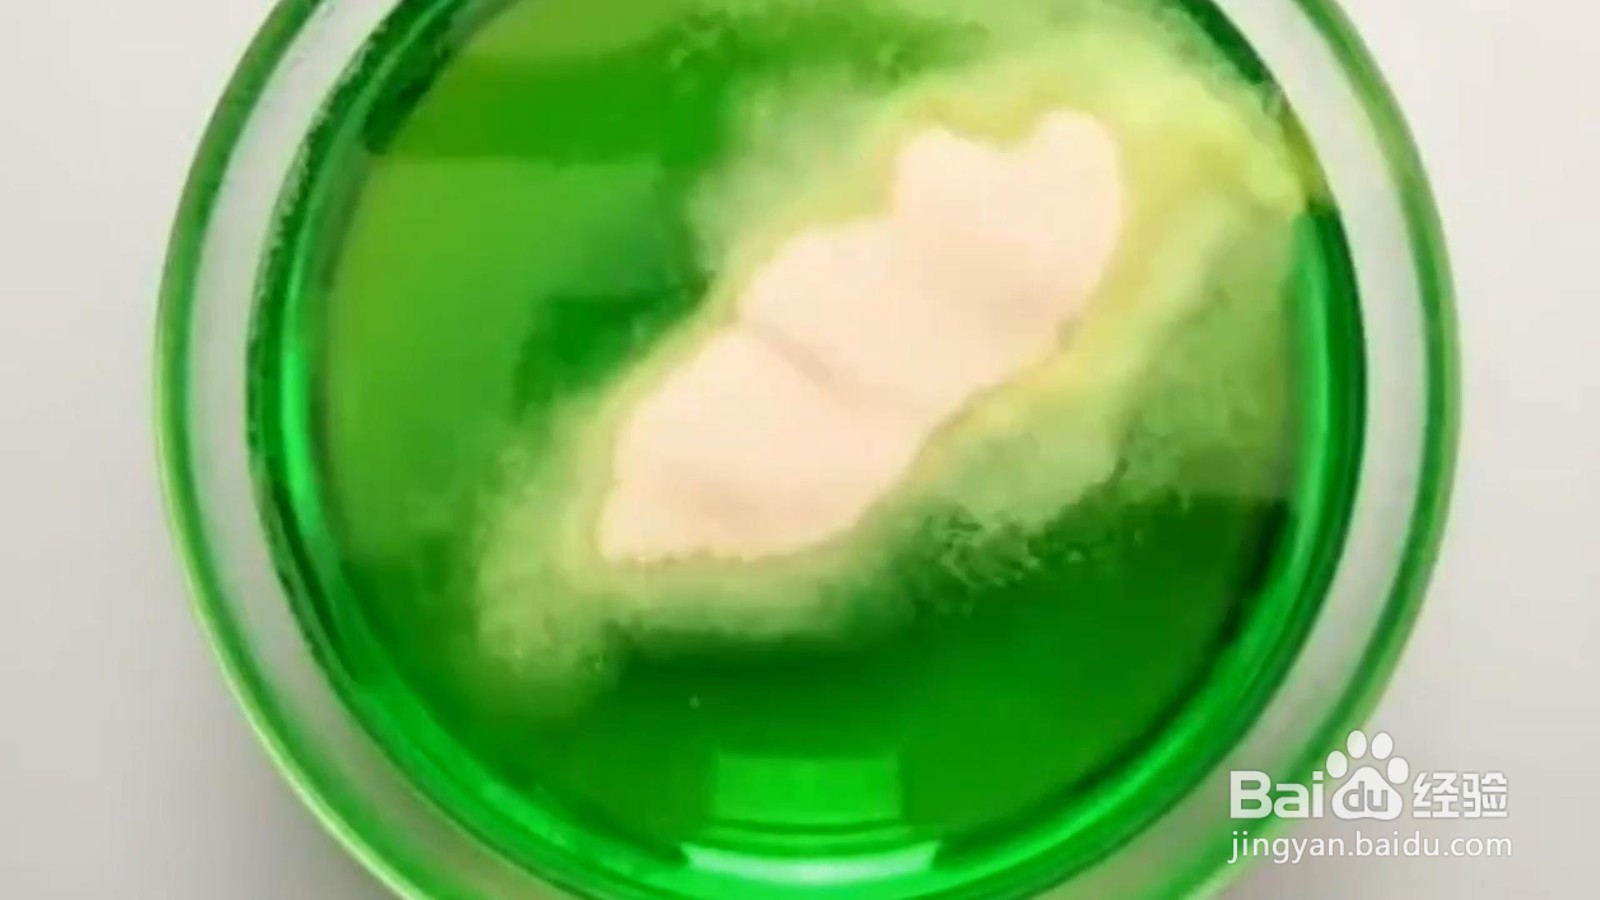
怎样制作好吃的小零食

怎样制作好吃的小零食
1、在容器中加入可乐和白砂糖,混合均匀。

2、倒入模具中,冷藏后,美味可乐冰就完成了。



3、碗中倒入雪碧,食用色素,淀粉混合。



4、倒入模具中,雪碧棒棒糖就完成了。


5、把苹果切成圈,裹上焦糖,裹上淀粉,油炸一下,美味苹果甜甜圈。



声明:本网站引用、摘录或转载内容仅供网站访问者交流或参考,不代表本站立场,如存在版权或非法内容,请联系站长删除,联系邮箱:site.kefu@qq.com。
1、在容器中加入可乐和白砂糖,混合均匀。

2、倒入模具中,冷藏后,美味可乐冰就完成了。



3、碗中倒入雪碧,食用色素,淀粉混合。

4、倒入模具中,雪碧棒棒糖就完成了。


5、把苹果切成圈,裹上焦糖,裹上淀粉,油炸一下,美味苹果甜甜圈。


